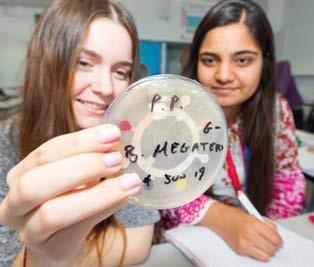

WE ARE RICHARD TAUNTON



WELCOME TO THE RICHARD TAUNTON SIXTH FORM COLLEGE PROSPECTUS FOR 2024/25.
IT COULD NOT BE A BETTER TIME TO JOIN US AS WE CONTINUE TO EVOLVE OUR TEACHING AND STUDENT EXPERIENCE AT A REMARKABLE PACE. THE FIRST CLASS LEARNING WE OFFER OUR STUDENTS GIVES THEM THE BEST OPPORTUNITY TO SHAPE THEIR CAREERS WHILE BEING NURTURED AND SUPPORTED TO BECOME THE BEST THEY CAN BE.
Our most recent OFSTED report applauded the way we foster a culture of respect, ambition and inclusivity –as well as preparing young people for future employment.
This is alongside the significant investment in our campus with extensive refurbishment work and the introduction of new state-of-the art-facilities for our T-Level provision.
Our new career-focused teaching in Adult Nursing, Digital and Esports are exciting developments and are just another reason why Richard Taunton is the ideal choice for the next step of your education journey.
What makes us unique is the value we place on encouraging our students to become fully engaged citizens and providing access to leading employer expertise, knowledge and opportunities through our pathways enrichment programmes.
Please do check out the news section on our website to read about some of the amazing things our students have done in the past year.
Making the transition into college can feel like a big step but at Richard Taunton Sixth Form College we provide just the right amount of support – while still letting you control your future.
We have an extensive range of study programmes to choose from, with the added advantage of being able to select the mix of A-Level and Vocational learning that is right for you.
Plus there is an active enrichment offer that gives you the opportunity to get involved in all aspects of college life. It’s a fantastic part of the Richard Taunton experience.
Richard Taunton Sixth Form College is proud to be part of the Lighthouse Learning Trust which delivers high quality education and training, creating opportunity for all.
Our values of respect, responsibility and ambition are embedded in everything we do with students, staff and all our business partners.
I have worked in education for more than 25 years and I am continually humbled by the achievements and attitudes of our students and staff across the trust and our wonderful college.

I am passionate about combining academic excellence with ambitious career goals to give our young people the very best start in their working life.
Shape your future with us. We look forward to welcoming you.
Angela Berry PrincipalAPPLICATIONS OPEN
You can now apply for your chosen course through our website. If you require a paper copy of the form please contact the admissions team who will be happy to send you one.
MONDAY 11 SEPTEMBER 2023
OPEN EVENTS
Attend an open evening, look around the campus, see your facilities, meet the teaching staff, find out all you need to know about the courses on offer. Parents are very welcome to come along too.
THURSDAY 28 SEPTEMBER 2023
6.00 - 8.30pm
THURSDAY 16 NOVEMBER 2023
6.00 - 8.30pm
SATURDAY 25 NOVEMBER 2023
11.00am - 3:00pm
WEDNESDAY 12 JUNE 2024
6.00 - 8.30pm
YOUR INTERVIEW
Your interview will usually take place within a few weeks of making your application. You will discuss your course choices, entry requirements and any enrichment options you would like to take.
WINTERFEST
Come along to our Winterfest event and enjoy live music, our Christmas Craft fayre, meet staff and students and enjoy the festivities.
SATURDAY 25 NOVEMBER 2023
11.00am - 3pm
APPLICANT DAYS
This is an opportunity to try out your chosen course of study, meet new friends who may be joining at the same time and meet your teachers and support staff.
THURSDAY 27 AND FRIDAY 28 JUNE 2024
9.00 am – 4.00 pm
ENROLMENT
Take
In advance of your GCSE results you will receive a letter inviting you in to attend enrolment. Here you will be able to finalise your courses, officially enrol as a RTSFC student. Congratulations!
23 - 30 AUGUST 2024
AT RICHARD TAUNTON SIXTH FORM COLLEGE, WE WILL CHALLENGE YOU TO BE THE BEST YOU CAN BE. OUR GOAL IS TO HELP YOU BECOME A WELL-ROUNDED INDIVIDUAL WITH THE SKILLS AND KNOWLEDGE TO SUCCESSFULLY PROGRESS ON TO YOUR CHOSEN DESTINATION. THE EXPECTATIONS WE HAVE ARE BASED ON THREE KEY WORDS:
In September, you will be joining a community full of polite and considerate young people who strive to do the right thing for themselves, for others, and for their surroundings.
As a college, we are committed to appreciating and celebrating the diversity of our students, staff and local communities.
From your first day at college, we expect you to always work to the best of your ability.

This means always having the correct equipment for lessons, being positive, punctual and having an open mindset. There will be opportunities to help prepare you for your next steps into university, employment or further training.
At Richard Taunton, we expect our students to have high expectations of themselves and work towards the ambitious goals they have set for themselves.
We know you will never settle for second best but always strive towards your best. We offer a full and diverse range of enrichment activities allowing students to make the most of the opportunities available to them.

BELOW IS A STEP-BY-STEP GUIDE THROUGH THE APPLICATION JOURNEY. THIS WILL BE USEFUL FOR YOU TO REFER TO THROUGHOUT THE YEAR AS YOU MAKE YOUR WAY TO THE NEXT LEVEL OF YOUR EDUCATION. LET YOUR PARENTS OR GUARDIANS TAKE A LOOK TOO SO THEY CAN HELP SUPPORT YOU THROUGH THE PROCESS. PLEASE NOTE THE DATES IN YOUR DIARY, WE WOULDN’T WANT YOU TO MISS OUT!
You can now apply for your chosen course through our website. If you require a paper copy of the form please contact the admissions team who will be happy to send you one.
MONDAY 11 SEPTEMBER 2023
During the Autumn term we spend a lot of time visiting schools. You might see us at a careers fair, or in an assembly. Take this opportunity to find out more about the college and what we offer. Ask us any questions you might have about starting college and tell us what you are interested in.
Our knowledgeable team will be able to offer you advice and guidance to help you make decisions about your future.
Attend an open evening, look around the campus, see your facilities, meet the teaching staff, find out all you need to know about the courses on offer.
THURSDAY 28 SEPTEMBER 2023
6.00 - 8.30PM
THURSDAY 16 NOVEMBER 2023
6.00 - 8.30PM
SATURDAY 25 NOVEMBER 2023
11.00AM - 3:00PM
WEDNESDAY 12 JUNE 2024
6.00 - 8.30PM
In advance of your GCSE results you will receive a letter inviting you in to attend an enrolment event. Here you will be able to finalise your courses and officially enrol as a RTSFC student. Congratulations!
23 - 30 AUGUST 2024
Your pre-enrolment interview will usually take place within a few weeks of making your application. You will discuss your course choices, entry requirements and any enrichment options that you would like to take.
This is an opportunity to try out your chosen course of study, meet new friends who may be joining at the same time and meet your teachers and support staff.
THURSDAY 27 AND FRIDAY 28 JUNE 2024
9.00 am – 4.00 pm
Our information, advice and guidance team as well as our careers advisors are on hand to talk through any of your concerns and options on the day of your results, just give us a call.
THURSDAY 22 AUGUST 2024
OUR FOCUS IS ALWAYS ON YOUR DESTINATION AND AMBITIONS, AND THIS MEANS GUIDING YOU TOWARDS YOUR LONG-TERM GOAL. OUR CAREERS TEAM OFFER IMPARTIAL CAREERS INFORMATION, ADVICE AND GUIDANCE THROUGH ONE-TO-ONE SESSIONS, WORKSHOPS, TUTOR SESSIONS, PROGRESSION DAYS AND MANY OTHER EVENTS. IT IS IMPORTANT YOU HAVE THE OPPORTUNITY TO EXPLORE THE MANY OPTIONS AVAILABLE TO YOU.
Work experience is an important part of your study programme and college experience, and all students should look to undertake some during their time at college. Placements will give you a great insight into the type of career you might be interested in and help you develop the skills needed for employment.
Work experience is also imperative for some higher education courses. If you are looking to study medicine, health and social care related courses or veterinary science, admissions tutors will look closely to see whether you have undertaken any work experience alongside your course. Doing so shows your commitment and dedication to the subject you are interested in, but also develops those soft skills that you might not get to use during your lessons.
If you are on a foundation study programme, or have chosen a professional course option, you will be required to complete work experience as part of your course. There is also a week during the summer term for all students to take part in work experience. We encourage students to find their own placements but support is also available through the careers team.
We can help students secure apprenticeships, by assisting with applications, any tests that applicants must undertake, as well as practice interviews and help with presentation skills.
Students have been offered places at prestigious companies such as IBM, Ernst & Young, Deloitte, Arqiva and Fiander Tovell.
There are many aspects linked to employability and we will offer you a menu of activities to make you more employable, whether this is to help you secure part time work, a work experience placement or getting that dream apprenticeship.
We will run a variety of workshops and events on the following topics:
• CV writing
• Application writing
• Cover letter writing
• Job seeking guidance
• Interview techniques
• Mock interviews.
Many of our students will progress on to university after college. We work closely with local universities (including Southampton, Solent, Winchester, Bournemouth and Portsmouth), as well as the Southern Universities Network project, to help our students from all walks of life achieve their goals.
Students will begin their UCAS application in the summer term of their first year to meet the January deadline. Help with university applications is available throughout the year and we have an excellent record for supporting student progression to highly selective universities.
For those on a foundation programme we hold progression days for students to explore the options available to them.
Please visit our website for more information about our courses.

OUR FOUR PATHWAYS WILL GIVE YOU THE DIRECTION AND FOCUS TO HELP ACHIEVE YOUR CAREER GOALS.
They are designed to open up opportunity and to help us guide you. It may be that you don’t yet know what your career aim is – that’s okay too because the pathways are interchangeable and contain the same core elements that make up your study programme.

We are lucky to have employer ambassadors who visit the college regularly to talk about careers and univerisity choices. You’ll have the opporutnity to talk over your ambitions with them and take advantage of their experience.
The pathway you choose will be based on a combination of factors, including your course of study, your aims for the future and your wider skills and interests. You will become part of one of our relevant career focused pathways.
These pathways are designed to enrich and grow your learning experience to ensure that you leave college with not only a qualification but experiences that will be related to your chosen career. You will also follow a programme of relevant work experience during your time with us.
Find your ideal job matched to your personality and a list of courses previous students studied in order to get there.
PATHWAY 1

Our creative pathway covers a whole range of disciplines, from design to dance and fine art to front of stage. This, combined with our digital offer, can lead you to a fantastic career in the technology world. There is a driving force behind technology now, the demand for jobs and people with the skills and knowledge to meet the needs of the digitally transformed industries are increasing rapidly.
PATHWAY 2
This pathway unlocks a huge number of opportunities in the medical profession, including doctor, nurse, veterinary, occupational health, medical scientist, dentist or researcher.
If you are thinking of a career in the environmental sector, then this is the pathway for you.
PATHWAY 3
If you are interested in serving community or country in the armed forces, police, or legal profession then this would be your pathway, and if you are focused on sport this would also work for you.
PATHWAY 4
For those who want a career in finance or the legal profession or take up a trade, then this is the pathway for you. It is also for those who are interested in leisure and/or travel.
THROUGHOUT THE DURATION OF YOUR STUDIES YOU WILL HAVE ACCESS TO AN EXTENSIVE RANGE OF SERVICES DEDICATED TO SUPPORTING YOUR HEALTH, WELLBEING AND LEARNING. OUR RANGE OF SERVICES AVAILABLE CAN GIVE YOU A HELPING HAND TO ENSURE YOU REACH YOUR POTENTIAL.
THE LEARNING SUPPORT TEAM WILL EQUIP YOU WITH THE TOOLS YOU NEED TO SUCCEED IN YOUR SUBJECTS.
Our team offers 1-to-1 sessions to identify areas in need of development and can create a tailored support plan to help you reach your targets. These sessions cover a range of areas, with everything from managing anxiety to essay writing skills.

The college supports students with a range of special educational needs. Depending on individual EHCP requirements, we can provide a personalised support programme including classroom support, which is regularly reviewed and evaluated to ensure it is effective and supports progress to independent learning.

Please get in touch with our learning support manager if you would like to discuss how we can support you.
Tel: 02380 514 784
Email: vinhah@richardtaunton.ac.uk
YOU WILL HAVE ACCESS TO AN EXTENSIVE RANGE OF DIGITAL SERVICES. OUR AIM IS TO MAKE SURE YOU’VE GOT THE DIGITAL SKILLS THAT WORK AND LIFE NOW DEMAND.
From video calls to document sharing, it’s never been easier to collaborate and connect with others. To achieve this, we use a range of digital tools, and where relevant, we’ll also give you access to specialist software packages like Adobe Creative Cloud.
We expect you to be an active member of your online classrooms and to talk to your teachers about your progress. All classes will be assigned a Microsoft Teams classroom where you can keep up to date with classwork, extended study, assignments and feedback from your teachers. You can also use MyPortal to check your timetable, track your attendance, and keep tabs on how your studies are going.
OUR SPACIOUS LEARNING AND DEVELOPMENT HUBS ARE GREAT PLACES TO STUDY, RESEARCH AND ACCESS THE SUPPORT YOU NEED TO ACHIEVE SUCCESS.
Our Development Hub will help you develop as a person; with the support you need now and for your future. Our student welfare and our careers and progression teams are all based within the hub and are always on hand to guide you in the right direction.

Our Learning Hub is focused on ensuring that you get the best from your Extended Learning time. Our experienced and friendly team can help you access a wide variety of resources which will support your learning. The learning support team are based here and facilitate our quiet reflection space – a ‘safe haven’ for students who need it. In this space you’ll have access to a wide range of resources dedicated to helping you succeed:

• Study materials – books, journals and subject guides, newspapers, magazines and remote access to electronic resources
• Zones for silent/quiet/general study
• IT facilities, including desktop computers, printers, photocopiers and scanners, DVDs and screens
A DEDICATED MEMBER OF THE STUDENT SERVICES TEAM WILL WORK WITH YOU AND YOUR PROGESS TUTOR TO ENSURE YOU GET THE MOST FROM YOUR STUDIES.
Your dedicated student welfare officer is there to help you if things get tough. If you are struggling with your mental health or you are feeling anxious about an exam, don’t suffer in silence, you always have someone who can help. You just need to talk to your student welfare officer, who will help you find a way forward.
You can also access the following support at college:
• Dedicated team of counsellors
• Workshops on how to manage anxiety or exams stress
• Dedicated online wellbeing resources and an online wellbeing hub
• Drop in sessions with No Limits.
Keeping everyone safe is our top priority and we have a team of staff making sure our learners stay safe, happy and healthy. Our dedicated safeguarding team is easy to spot as you wander around the college, as its members are the ones wearing rainbow-coloured lanyards.
If something is happening in your life and you are worried about your safety, you can talk to one of our safeguarding team, or any member of staff you feel comfortable talking to, and they will make sure you get the help you need.
IT’S TIME TO STEP THINGS UP A GEAR. LIFE AT COLLEGE DIFFERS FROM SCHOOL IN A FEW WAYS. WE GIVE YOU A LOT MORE INDEPENDENCE AND RESPONSIBILITY BECAUSE WE WANT YOU TO SUCCEED IN THE LIFE AND THE WORLD THAT LIES BEYOND COLLEGE. SO, WHAT CAN YOU EXPECT FROM A DAY IN THE LIFE OF A RICHARD TAUNTON STUDENT?
Lessons will range in length from one hour to three hours depending on your choice of subject and level of study. There are no bells; we expect students to manage their own time. You are free to call your teacher by their first name, and we encourage you to take more responsibility for your own learning to match the increased level of freedom that you have at college.
AS A COLLEGE STUDENT, YOU’LL SPEND AS MUCH TIME STUDYING OUTSIDE THE CLASSROOM AS YOU WILL INSIDE. AT RICHARD TAUNTON WE CALL THIS EXTENDED LEARNING.
You will have timetabled sessions to help you make the best use of your time outside of your taught sessions, you’ll have access to our great study facilities and friendly staff who will be on hand to help you achieve your independent learning goals.


AS PART OF YOUR STUDY PROGRAMME, YOU WILL HAVE ONE UPSKILL SESSION WITH YOUR DEDICATED PROGRESS TUTOR EACH WEEK.

As part of these sessions, we will help you develop the eight skills that are recognised as being key to you being successful in finding a job in the future. Want to be a lawyer, or an architect or maybe even a musician? How are you going to stand out against the crowd? Upskill will help you do that.
The programme will cover a wide variety of topics linked to your personal development, but all of the sessions will link back to those eight key skills you need to stand out against the crowd.
Upskill sessions will:
• Help you develop your independent study skills
• Cover a range of personal, social, health and economic topics
• Teach you more about the world of work and your progression options.
As part of the Upskill programme, you will also have a regular 1-to-1 session with your dedicated progress tutor who will help you break down any barriers you may be facing and work with you on where to go with your next steps.
ENRICHMENT IS SOMETHING THAT IS BUILT INTO YOUR STUDY PROGRAMME. IT WILL ENHANCE YOUR STUDIES, GIVE YOU CONFIDENCE AND HELP YOU ACHIEVE YOUR GOALS.
Enrichment comes in many forms. You might be part of a team or society, take part in pathway specific activities alongside your subjects, or you might want to start your own club.
Whether you want to try your hand at something creative, or you’re more of an active person, there will be something for you. Whatever it is you want to achieve at college, there will be an enrichment option to help you get there.

For more information about what’s on offer, turn to page 16.
You may be eligible for assistance with travel, a meal allowance in our café, or the loan of an electronic device. For more information, please visit our website or contact our Student Services team on: 02380 514720 or studentadmin@richardtaunton.ac.uk
ENRICHMENT FORMS A KEY PART OF YOUR STUDY PROGRAMME, AND YOU ARE EXPECTED TO UNDERTAKE AT LEAST ONE ENRICHMENT OPTION THAT IS CONNECTED TO THE PATHWAY YOU HAVE SELECTED. IN ADDITION TO THIS YOU CAN TAKE PART IN AS MANY OTHER ACTIVITIES AS YOU LIKE.
Whether it’s a club, society or a team sport that you are interested in joining or starting up, the skills you will get from enrichment give you the confidence and skill which will help you in your studies and beyond. Take a look below at some of the things you could get involved in at college.
Our students have an important role in shaping what the college looks like, and student voice is very important to us. Are you an aspiring leader? You might want to become a student rep, or student president or even a college governor. Talk to your progress tutor when you start with us.
We are always looking for students to represent the college at events such as Open Evenings, Taster Days and visits to local schools. Each ambassador receives training and can put these new skills into practice throughout the year. Being an ambassador really helps to build your confidence, particularly when it comes to public speaking, and looks great on your UCAS application and CV.
At Richard Taunton, there’s lots to choose from, including basketballl, boxing, dance, rugby, weightlifting and more. Our students and sports teams compete (and win) at county, regional, and national levels. Do you already compete in a sport at junior or senior national level? Learn more about how we can support you by visiting the sports department at our next open evening.
It’s important to balance your college studies with recreational activities. Not only is joining a club or society a great way to relax, it’s also a good opportunity to make some new friends. Every year there is something different, and you can also set one up yourself too. Take a look at a few of the clubs from the past couple of years: Dungeons and Dragons, Chess Club, Esports, Scrabble club, Book Club, Christian Union, LGBT Group and Pen to Paper (Creative Writing).
Pathway activities are a mandatory part of your course, you will need to choose at least one option which will form your study programme. Before you enrol at college we will give you the full list of options for when you start college. See pages 10-11 for more information about pathways. Here are a few examples of what might be on offer:
• Art workshop
• Coding and programing
• Media broadcast
• College production
• Music (choir)
• Creative writing.
• Brilliant Club
• Young medics
• Sustainability
• CIS and forensics.
• Volunteering
• Into teaching.
• Sport clubs and teams
• Young enterprise
• Debating.
PLEASE NOTE: enrichment offerings vary each year depending on demand and interest.
If you are interested in something that isn’t on our enrichment list, please let us know. We might be able to help you set up a new club or activity.

WHEN YOU APPLY TO RICHARD TAUNTON, WE WORK CLOSELY WITH YOU TO MAKE SURE YOU ARE ENROLLED ON THE COURSES THAT BEST SUIT YOUR STRENGTHS, INTERESTS AND ASPIRATIONS.
If you are unsure about where to begin when choosing your courses, don’t worry. The information on this page is a great starting point.
• Mainly A-Level courses
• More theoretical and written work
• Predominantly exam based
• Usually examined at the end of your second year of study
• Three subjects can be studied
• Students progress to university, employment and further study.
• Vocational qualifications such as CTECs, BTECs and T-Levels
• More applied/practical
• Mixed assessment methods
• Usually assessed throughout both years
• One to three subjects studied
• Many require compulsory work experience
• Students progress to higher education, employment and further study.
Most of our students study three Level 3 courses. Academic and professional courses can be studied alongside one another.
The time you spend at college is very short in comparison to your working life, but the courses you choose to study with us can have a big part to play in shaping your future. When considering your next steps, it can be helpful to begin with the end in mind. For example, if you already have a career path, university course, or higher apprenticeship in mind, do some research. They may have entry requirements that influence your college course choices.
Think about the subjects you enjoy and do well in, as this will motivate you to succeed.
We offer courses you may not have studied before. Be sure to explore these new options as they may relate closely to your interests and aspirations.
Your ultimate decision should be one you are happy with.
Keep an eye on application deadlines, but don’t feel the need to rush – it’s important to attend a range of Open Evenings and explore what is on offer.


No matter what level you join us at, there are great progression opportunities. Take a look at the routes below to see which one you might fit into.
This two-year study programme is made up of three academic subjects, the professional equivalent, or a combination of both.
Our professional courses fall into three categories: single (equivalent to one qualification); double (equivalent to two qualifications or, triple (equivalent to three qualifications).
Our Level 3 courses will give you the skills and knowledge needed to progress onto university, an apprenticeship, or employment.
This one year study programme is designed to help you build the skills and knowledge required to progress onto further study at the college. You will develop your study skills in preparation for Level 2 or 3 study.
Level 1 study programme: This programme will help you develop the skills needed to be successful in the workplace. You will take a diploma in vocational studies, alongside English and Maths courses.

Level 2 study programme: This will comprise of any necessary repeats of Maths and English alongside a vocational subject and work experience.
At least five GCSEs at grade 4 or above, including English.
At least four GCSEs at grade 3 or above, including English.
There are no formal qualifications needed, just a willingness to learn and enthusiasm to develop your aspirations.
PLEASE NOTE: Some courses have additional requirements, so be sure to check each course individually.


Studying this course will prepare you to produce detailed financial statements for sole traders, partnerships, and limited companies. You will also gain an insight into how these statements are used by a variety of stakeholders to assess the performance of their businesses. This is a subject that can open the door to a variety of career options.
• Double entry bookkeeping
• Sole trader accounts
• Limited company accounts
• Evaluation of financial statements
• Costing.
At least five GCSEs at grade 4 or above, including a grade 4 in English and a grade 5 in Maths.


The Acting course provides an opportunity to immerse yourself in different performance styles and experiment with different approaches.
The course provides various performance opportunities to allow you to work with different professional companies and in different approaches. You will be given opportunities to perform both in our performance studios and also in professional venues within the city.
• Acting styles (naturalism, physical theatre, political theatre)
• Devised theatre
• Improvisation
• Film and TV acting
• Performing in professional theatre.

At least five GCSEs at grade 4 or above, including English.
Gain a deeper understanding of the civil court system and criminal law, as well as the way law impacts every facet of our lives. You will learn to apply the legal concepts in a practical and theoretical way and develop skills in analysis, case research, and independent thinking.
• How laws are made and influences on legislation
• Legal professionals, legal advice, and funding
• Elements of crime (non-fatal offences, homicide, property offences)
• Police powers and sentencing
• Formation of marriage, divorce and maintenance.
At least five GCSEs at a grade 4 or above, including English.
LEVEL 3 - SINGLE
Explore the application of scientific knowledge to physical environments, and how it can be related to a number of different industries. Build on your knowledge of biology, chemistry, physics and scientific techniques. You will gain an understanding of how to perform experiments, analyse data, and draw conclusions.

• Practical scientific techniques
• Physiology of human body systems
• Waves in communications
• Cell biology
• Key concepts within biology, chemistry, and physics.
At least five GCSEs at grade 4 or above, including English, Maths, and a science.
Broaden your knowledge of the major systems of the human body, explore the interactions of organisms in their environment, and learn about the principles behind evolution and genetics through a fascinating course that brings a deeper understanding of living things.
• Biological molecules
• Cells and immunity
• Gaseous exchange systems in different organisms
• The cardiovascular system
• DNA, protein synthesis and genetics.
At least five GCSEs at grade 4 or above. Including science (Biology or Combined Science) and English and Maths at a grade 5.
During this course you will learn how different business theories relate to the operation of real-life businesses.
You will gain a critical understanding of organisations, the markets they serve, and the process of adding value. Having a good understanding of business and business practice is a valuable skill for a number of different career paths, including self-employment.

Single and Double
• Exploring Business
• Developing a Marketing Campaign
• Recruitment and Selection
• Personal and Business Finance.
Double only:
• Managing an Event
• International Business
• Principles of Management
• Team Building in Business.
At least five GCSEs at grade 4 or above, including English and Maths.
Please visit our website for extra information about each course.
Gain an introduction to the main elements of business, including marketing, finance, operations, and human resources, and explore how these contribute to reaching business objectives.
The course encourages the practical application of business concepts by exploring events in the business world and relating them to theories and practice to get a real-world appreciation of commerce.

• Objectives and strategy
• Marketing
• Accounting and finance
• Human resources
• Operations management.
At least five GCSEs at grade 4 or above, including English and Maths.

A-LEVEL
This course brings chemistry to life as you explore the properties and interactions of substances that form the building blocks of matter. You will also participate in a wide range of hands-on chemistry practicals in our well-equipped labs to understand chemistry’s role in many fields, including medicine, engineering, and the environment.

• The structure of atoms, compounds and molecules
• The periodic table
• Analytical chemistry
• Physical chemistry
• Organic chemistry.
At least five GCSEs at grade 4 or above. Including science (Chemistry or Combined Science) and Maths at a grade 6, and English at grade 5.
A-LEVEL
This practical subject will develop the capacity to think creatively, innovatively, logically and critically.
You will study a broad range of topics and apply the academic principles learned in the classroom to real-world situations to gain an understanding of how computer scientists design and develop the software that is becoming ever more central to the way we live.
• Contemporary processors, input, output and storage devices
• Elements of computational thinking
• Programming and problem solving

• Algorithm design and efficiency
• Legal, moral, cultural and ethical issues.
At least five GCSEs at grade 4 or above, including English, Maths at a grade 6, and either science (Physics or double award) or Computer Science at grade 6.
LEVEL 3 - SINGLE
Have you ever wondered why people commit crime? What happens when investigations go wrong? Or how DNA is used to catch criminals? Criminology will teach you to be able to answer all of these questions and much more over your two year course.

You will learn to apply theoretical understandings to real life criminal cases as well as be able to evaluate the use of different agencies within the criminal justice system.
• What is crime?
• Campaigning for change
• Theories of criminality
• Processes of criminal investigations
• The role of punishment in a criminal justice system.
At least five GCSEs at grade 4 or above, including English.
Please visit our website for extra information about each course.
Deepen your understanding of human anatomy and dance history and develop your skills in dance technique and analysis. This highly practical course is a fantastic way to improve your technical and choreographic skills and become a more competent and confident performer.

This course has been designed to prepare you for a career in the dance and performing arts industry. You will have opportunities to take part in workshops with industry professionals, be part of our college dance company and perform within our annual musical productions and showcases. You will also have full support from our experienced teachers in auditioning for drama schools and any future career you wish to endeavor.
• Contemporary dance technique
• Choreography
• Learning professional repertoire
• Healthy performer
• Dance history.
At least five GCSEs at grade 4 or above, including English.
Develop your creativity by studying a digital media course based on realistic workplace situations, activities, and demands.
You will gain an understanding of the media industry through analysing media representation and pitching and producing media projects. Using programmes including InDesign and Premiere Pro will provide the practical experience demanded by the media industry.
• Print based media production
• Video based media production

• Advertising
• Web design

• Scriptwriting.
At least five GCSEs at grade 4 or above, including English.

A-LEVEL
Uncover the causes of the major economic crash in 2008 and evaluate the UK’s decision to leave the EU on this fascinating economics course.

You will explore the micro and macro economy, both on a national and global scale, and learn about how scarce resources are allocated.
You will also gain an understanding of the challenges governments face in dealing with globalisation, pollution and ageing populations.
• How markets work
• Why markets fail
• How the economy works
• Government use of fiscal and monetary policy
• International trade.
At least five GCSEs at grade 4 or above, including a grade 4 in English and a grade 5 in Maths.
A-LEVEL
You will study a variety of interesting texts in depth by analysing how language is used to create meaning, and how contexts can shape a text.

You will also explore your own writing skills by creatively using language to communicate in different ways.
• Voices in speech and writing
• Writings in language and literature
• Original writing
• Textual analysis.
At least five GCSEs at grade 4 or above, including English.
The Esports Industry is a fastgrowing multi-million global industry. This qualification will give you a comprehensive insight into the professional field of organised competitive computer gaming, which is human vs human, either as individuals or in teams. This course will provide an opportunity for the integration of social, physical, mental and financial skills into one qualification to deepen and expand your learning.

These are skills that are highly valued in the changing and fluid workplace. You will be able to apply strategy, skill and teamwork to become highly successful.
• Esports skills, strategies and analysis
• Enterprise and entrepreneurship
• Health, wellbeing and fitness
• Esports events
• Broadcasting and shoutcasting
• Video production and games design
• Esports coaching
• Computer networking.
At least five GCSEs at grade 4 or above, including English and Maths.
Explore and develop your drawing and painting ability and experience a diverse range of mixed-media techniques to an advanced level on this challenging and engaging course.
You will develop the skills and ideas needed to create original and personal artwork, using your first-hand experiences and a study of other artists to help you develop your portfolio.
• Line, tone and texture
• Exploring surface building
• Thematic unit
• Colour
• Artist and concept.
At least five GCSEs at grade 4 or above, including English and Art. A suitable portfolio of artwork may be accepted as an alternative to GCSE Art.

Have you ever thought; What will be the impact of future climate change and is there anything I can do about it?
If we are living in an Ice Age, will the glaciers ever come back? If cities are so good for creating wealth, why are they not full of just rich people?
Does the World Bank solve or create global problems? If you study Geography you will understand how people’s lives are affected by the world in which we live and explore the big environmental issues that challenge our future.
• Cycles that sustain life of earthwater and carbon
• Modern life in towns and citiesurban environments
• Why some places feel special?Changing places
• Winners and losers - global systems and governance
• What happens when the world is frozen? - Glacial systems and landscapes.
LEVEL 3 - SINGLE
A combination of art and technology, graphic design will develop your skills in creative problem solving. This course explores the fundamentals of graphic design and provides a concise introduction to working in the design industry.

You will have the opportunity to learn new computer editing skills while presenting an individual response to design briefs.
INCLUDE
• Art analysis
• Photo manipulation
• The role of graphics in marketing
• Typography
• Motion graphics and 3D design
• Photography and print media.
At least five GCSEs at grade 4 or above, including English. A suitable portfolio of creative work may be accepted as an alternative to GCSE Art & Design.
Please visit our website for extra information about each course.
At least five GCSEs at grade 4 or above, including English and Maths.

This challenging and rewarding course will help prepare you with the practical skills needed for a range of careers in the health and social care industry.
You will explore a variety of topics and themes such as additional needs, causes of disease and the role of professionals. You will also learn practical skills such as how to undertake risk assessments, training in safeguarding and first aid.
• Human development
• Working in health and social care
• Physiological disorder
• Meeting individual care needs.
At least five GCSEs at Grade 4 or above, including English, Maths and a science (Single or Double Award). Students must have a DBS check carried out before starting the course.
An exciting way to gain academic knowledge as well as undertake practical work placements. The technical qualification will include core theory, concepts and skills for the industry and specialist skills for adult nursing as a career. The college has invested in brand new state of the art nursing facilities to provide professional standard training.

• The principles and applications of working in the health setting
• Working with health and science
• Human health
• Safety and environmental regulations
• Good scientific and clinical practice
• Core science concepts.
*The course also includes 315 hours in an industry placement and completing occupational specialisms, including supporting the Adult Nursing Team.

At least five GCSEs at grade 4 or above, including English and Maths.

Did Hitler have a plan? Were Stuart Kings really seen as gods? Did African-Americans really gain equality in America? These are some of the important questions that we explore in A-level History. If you enjoy debate, discussion or even an argument and have a keen interest in the past and how it shaped the present then this may be a subject you will enjoy! These are some of the important questions that we explore in A-level History. Deepen your understanding of the people and events that have shaped the world we live in today. Through three fascinating periods in history you will explore themes that have resonance right now and discuss their repercussions.
• Stuart Britain and the crisis of the monarchy
• Democracy & Nazism (1918-1939)
• Civil rights in the USA (1870-1970).
At least five GCSEs at Grade 4 or above, including English.

Learn how you can meet the demands of the information age, where knowledge of how technology is ever more integral to our world. This course will explore a variety of topics, from the relationship between hardware and software, to managing and processing data and using it to communicate and share information. Practical tasks will also develop transferable skills which can be used to access university or employment.
• Information technology systems
• Creating systems to manage information
• Using social media in business
• Website development.
At least five GCSEs at grade 4 or above, including English and Maths.

Please visit our website for extra information about each course.

If you enjoy analysing and solving problems, want to learn more about software design and development, and are excited by the emerging technical trends such as Artificial Intelligence and Augmented Reality, then this could be the course you’ve been looking for!
Studying this T-Level will help you develop an understanding of a broad range of issues relevant to the digital sector. You will gain the skills and knowledge you need to succeed in the workplace by spending 315 hours in industry placement during your course.
• Ethical and moral implications

• Digital environments: including physical, virtual and cloud
• Internet security
• Testing software, hardware and data
• Designing and testing software
• Changing, maintaining and supporting software
• Creating solutions.
At least five GCSEs at grade 4 or above, including English and Maths.

Discover the workings of the English legal system, looking at both the procedural and substantive side of the law. You will explore criminal law, including case law and legislation, tort law, and human rights law, as well as the systems and processes which underpin our legal conventions, such as precedence and how judges interpret statutes.
• The English law system
• Criminal law
• Tort law
• Human rights law
• Concepts of law.
At least five GCSEs at grade 4 or above, including English and Maths.

Explore how mathematical ideas are interconnected and how it can be applied to model the real world. You will look at mathematical argument, language and problem solving –working with your peers on activities and presentations in the classroom and online. You also have access to our onsite Maths hub during your spare time.

• Calculus
• Proof
• Logarithms
• Hypothesis testing
• Mechanics.
At least five GCSEs at Grade 4 or above, including English and a grade 6 in Maths.
With the introduction of affordable recording technology, the traditional career path of working full-time in a recording studio is being replaced by a multi-income stream approach.
To carve out a career in the music industry you need to be able to record, compose, create sound design, remix, produce, and work collaboratively with other music creators.
This course will give you the skills and knowledge to work in the music industry.

• Sequencing
• Mixing and mastering
• Creating music and sound for film and games
• Remixing
• Using the recording studio.
At least five GCSEs at grade 4 or above, including English. Grade 5 Music Theory is useful but not essential.
If you have an interest in and commitment to the performing arts then you will thrive on this practical course. You will get the chance to explore the development of skills in all three performance disciplines.
This is achieved through sessions in Dance, Vocals and Acting with specialist teaching staff.
The course is designed to help prepare you for a career in the industry and has a very practical focus. You will be offered a variety of performance opportunities throughout the year which culminate in the end of year musical production.

Single and Triple:
• Performing arts skills development
• The performing arts business. Triple only:
• Principles of performance
• Engaging with an audience
• Professional practice
• Production skills and context.
At least five GCSEs at grade 4 or above, including English.
Sharpen your approach to capturing an image and gain an understanding of the professional world of photography. Explore the practical and aesthetic aspects of photography and learn from the ideas and techniques of other photographers. Work will be primarily digital but you will also have the opportunity to gain experience of working with creative darkroom processes.
• Camera controls and settings

• Darkroom hand rendering techniques
• Photoshop editing techniques
• Mixed media experimentation
• Capturing movement.
At least five GCSEs at grade 4 or above, including English and Art. A suitable portfolio of creative work may be accepted as an alternative to GCSE Art.

Please visit our website for extra information about each course.
A-LEVEL
This challenging and rewarding course delves deep into the fundamental nature of the universe and looks at how we can explain and mathematically model the myriad phenomena that exist in nature. Spanning the behaviour of subatomic particles to understanding the entire universe, learn how physics is at the heart of our very nature.
• Nuclear radiation and nuclear decay
• Quantum theory
• Mechanics – forces and motion
• Electric, magnetic and gravitational fields
• Stars and the universe.
At least five GCSEs at Grade 4 or above, including Maths and Science (Physics or double award) at Grade 6 and English at Grade 5.
This practical and creative course will develop your performing skills as a soloist and as a member of a group. You will learn about how to begin your career as a professional musician, the history of rock and pop music, and will build on your notation, listening and songwriting skills. Additionally, you will take part in live performances both in and outside of college as well as organising and running gigs yourself.
Single and Double:
• Rehearsal, and performance skills
• Performing live
• Improving your musicianship
• Working in the music industry
• Solo performances.
Double only:
• Songwriting
• Music theory
• Performing as a session musician
• Music event management.
At least five GCSEs at Grade 4 or above, including English. All applicants are required to attend an audition.

A-LEVEL
Learn how to conduct psychological research, analyse data, and formulate conclusions, as well as applying psychological theories to real life. This course takes a scientific approach to learning about key research and understanding behaviour.

• Seven key psychological areas and social, biological and psychodynamic perspectives
• Research methods and data analysis
• Clinical psychology
• Child psychology
• Environmental psychology.
At least five GCSEs at grade 4 or above, including Maths, a science, and English.

Question what happens in society and search for explanations concerning what influences our behaviours and why. This course involves the study of human society, culture, and relationships. You will examine current affairs, how society works, and the people within it. Learn how to draw on a range of perspectives, evidence and contemporary issues to prepare you for university and employment.
• Socialisation, culture and identity
• Media
• Research methods
• Social inequality: social class, gender, ethnicity and age
• Globalisation and the digital social world.
At least five GCSEs at grade 4 or above, including English.

This exciting and skills-driven course involves a combination of academic study and practical sport to equip you for working in a teaching or coaching industry. This course gives you work experience within the Saints Foundation. You will also undertake the FA Level 1 Coaching in Football Certificate, the Level 2 Multi Skills Award and the Junior Football Leaders Award.
TOPICS INCLUDE
• Health, wellbeing and sport
• Coaching skills
• Sport development
• Organising sports events
• Careers and self-employment in sport.
*The nature of this course means it fills an entire timetable in a similar way to a Triple Award.
At least five GCSEs at grade 4 or above, including Maths and English.

Explore the physiological and psychological aspects of sport by combining academic study with playing both team and individual pursuits. You gain an understanding of the knowledge and skills required for a successful career in the sporting industry with experience of speaking in front of groups, planning and delivering different practical activities.

TOPICS INCLUDE
• Coaching
• Health, wellbeing and sport
• Employment in sport and physical activity
• Sports development
• Anatomy and physiology.
At least five GCSEs at grade 4 or above, including English.
Please visit our website for extra information about each course.
Please

LEVEL 3 - SINGLE
Equip yourself for a career in sport with practical experience in sport science and disciplines including biomechanics, coaching, and psychological profiling. You will learn about anatomy, nutrition, physiology and fitness training. By developing your confidence, knowledge, and skills, you will also become better prepared for a number of careers in the sporting industry.

• Biomechanics
• Applied psychology
• Anatomy and physiology
• Training and fitness
• Massage.
At least five GCSEs at grade 4 or above, including Maths, English, and a science.

Develop your interest in colour, pattern, shape, form, texture, and decoration with this hands-on course. Practical workshops in printed, dyed and constructed textile design will develop your enjoyment of textiles and, through 2-D work and your sketchbook, produce a varied and experimental portfolio of textile-based art.
• Textiles in context (artist research)
• Urban life
• Patterns and structures
• Surface and textures
• Thematic building.
At least five GCSEs at grade 4 or above, including English and Art. A suitable portfolio of creative work may be accepted as an alternative to GCSE Art.
LEVEL 3SINGLE & TRIPLE
Get hands-on experience of the physical and mental challenges of a career in the uniformed protective services. Participate in a number of adventure activities including climbing and canoeing, as well as an overnight camping expedition. Hear first-hand accounts from outside speakers and visit a range of protective services to deepen your understanding and inform your career choices.

Single and Triple:
• Behaviour and discipline
• Teamwork and leadership
• Outdoor adventurous activities. Triple only:
• Expedition skills
• Managing security threats
• Criminal investigation procedures
• Developing personal fitness programmes.
At least five GCSEs at grade 4 or above, including English.


LEVEL 2
Prepare for the challenges and excitement of a career in business and hone your entrepreneurial skills by studying real-life companies and understanding how they use business theory in a practical way.
You will receive hands-on experience through work placements to prepare you for study at Level 3 or further training.

• Enterprise in the business world
• Finance for business
• Promoting a brand
• Recruitment, selection and employment
• Principles of marketing.
At least four GCSEs at grade 3 or above, including English.
LEVEL 2
Develop your technique and confidence in painting, drawing, photography, image manipulation, and animation.
As well as developing transferable skills, you will research artists, photographers and the media industry and receive course-related work experience to prepare you for study at Level 3 or further training.
• Painting and drawing
• Working with natural forms, abstract art, and experimentation

• Graphics and poster design
• Photography and photo manipulation.
At least four GCSEs at grade 3 or above, including English.
If you have taken GCSE English Language at school but not yet achieved a grade 4, this course gives you the opportunity to improve your result.
You will develop your speaking, listening, reading and writing skills throughout this course. You’ll read and discuss a range of texts, write about material you have read and produce your own pieces of original fiction and non-fiction writing.

By the end of this course you will have read a wide range of texts fluently and with good understanding, and be able to critical analyse them. You will also use knowledge gained from wider reading to inform and improve your own writing.
• Critical analysis of texts
• Using grammar correctly
• Punctuate and spell accurately
• Use spoken Standard English effectively.
English Language at grade 3.
The esports industry is a fast-growing multi-million global industry.
If you are interested in focusing your learning and career development within the world of Esports and IT, and are looking for an exciting, engaging and stimulating qualification, this course is an ideal starting point. By developing essential skills, techniques and attitudes, you will be better prepared for success in the workplace and advancement into employment.

• Esports games
• Teams and tournaments
• Establishing an Esports organisation
• IT software installation and upgrade.
Five GCSEs at Grade 2 or above. If you have not yet gained Grade 4 in English and/or Maths, this will form part of your programme.


LEVEL 2
Build your knowledge and understanding of health and social care practices and develop the professional and personal skills that are required for working in the sector. The course is an ideal starting point if you are interested in a future in nursing, midwifery, and social work or similar.
You will receive hands-on experience through work placements to prepare you for study at Level 3 or further training.

• Principles of working in health and social care
• Health and safety in practice
• Working in a person-centred way
• Safeguarding.
At least four GCSEs at grade 3 or above, including English.
LEVEL 2
This course will introduce you to the basic concepts and theories of law and criminology.
You will also learn skills which will support you in your future study.
This course is the perfect introduction for those who wish to pursue a social science or humanities subject at Level 3.
Law
• English legal system
• Powers of police officers
• Different types of crime
• Prosecution
• Sentencing.
Criminology
• Crime and deviance
• Data on crime
• Criminal justice system
• Social aspects impact e.g. the media.
At least four GCSEs at grade 3 or above, including English.

In GCSE Maths we help you to develop a positive attitude to mathematics and an appreciation of the place of maths in both employment and everyday life.
You will learn to think mathematically, to understand mathematical ideas and how to use them. Mathematics will help develop your analytical and problem solving skills.
• Number work e.g. Fractions, percentages
• Algebra
• Ratio and proportion
• Geometry and measure e.g. Area, volume, angles, Pythagoras’ theorem
• Probability
• Statistics – charts, graphs, averages.
This course is for students who have not yet achieved a grade 4 in GCSE Maths at school.


Learn fundamental elements of music and develop your instrumental/vocal skills while gaining an understanding of how the music industry works. You will perform in front of live audiences and receive hands-on experience through work placements to prepare you for study at Level 3 or further training.
• The performing arts industry
• Composition techniques
• Improvisation techniques
• Solo performance
• Ensemble performance.
At least four GCSEs at grade 3 or above, including English.
GCSE DOUBLE
Gain an understanding of core science concepts in biology, chemistry and physics. Explore environmental, physical, and life sciences while developing your investigatory skills.

You will receive hands-on experience through work placements to prepare you for study at Level 3 or further training.
• Human biology (body systems, diseases and genetics)
• Plant biology including ecology
• Chemical reactions
• Atomic structure
• Physics (energy, electricity, forces and waves).
At least four GCSEs at grade 3 or above, including English and a science.

Gain an insight into careers in sport and public service as we study a range of units which can support progression onto Level 3 courses and into the workplace. Throughout the course you will focus on gaining the skills required for these progression routes whilst developing your team work and leadership skills. You will also have the opportunity to develop your practical skills in sport.
• Participating in sport
• Anatomy and physiology for exercise
• Healthy exercise and nutrition
• Outdoor and adventurous activities
• Planning and running a sports event.
At least four GCSEs at grade 3 or above, including English.
THE VOCATIONAL STUDIES PROGRAMME IS TAKEN OVER A YEAR AND IS AIMED AT STUDENTS WHO HAVE ACHIEVED GRADES 1 OR 2 IN THEIR GCSES. UPON SUCCESSFUL COMPLETION, STUDENTS CAN PROGRESS ON TO A LEVEL TWO PROGRAMME OF STUDY.
This course will provide supportive learning in a small group and develop a range of academic, personal and social skills needed for further vocational studies and employment. The subject enables you to understand demands of different vocational subjects as you complete units in Business, Travel and tourism, Media and Health and Social Care.
You will complete a range of units tailored to your needs and interests.
• Exploring travel and tourism
• Advising others on healthy lifestyle
• Preparing a business plan
• Media – shooting a short promotional video.
Key skills you will develop are:
• Teamwork
• Leadership
• Presentation
• Communication
• Research.
Each unit you undertake supports the development of your literacy and numeracy skills.
As part of your programme you will undertake qualifications in English and maths. These will provide you with the foundation skills required to progress on to a level two study programme.

English
This course will equip you with the foundation skills of reading, writing, speaking and listening. You will explore non-literary texts, produce written work in various formats and styles and have discussions on topical issues.
This course will provide you with life skills for everyday maths. Examples of topics covered include: calculating/ analysing data, probability, decimals, fractions, percentages, volume, measures, table and charts as well as money, approximation, areas and perimeter.
RICHARD TAUNTON SIXTH FORM COLLEGE IS LOCATED IN THE VIBRANT, CULTURAL CITY OF SOUTHAMPTON. THERE ARE A RANGE OF TRAVEL OPTIONS STUDENTS CAN USE TO GET TO OUR CAMPUS.
Our shuttle bus service is free to all students. It stops at the Isle of Wight ferry terminal, West Quay, Southampton Central and the college.
Private and publicly operated bus routes make the college easy to get to. For more detailed routes and current timings, please visit our website.
We also recommend taking a look at local services provided by Bluestar and Xelabus for routes that stop near the college.
Cycling is a popular form of transport among our staff and students. We have a secure compound to store bikes, plus showers and changing facilities.
We have 155 parking spaces available to students on a first come first served basis.
Southampton Central is our nearest train station, with direct routes from Totton, Eastleigh, Romsey and Winchester. From the station, students can walk or catch the free shuttle bus service to the college.
You may be entitled to help with the cost of your travel. For more details please contact Student Services on 02380 514720 or studserv@richardtaunton.ac.uk
1 R903 Bluestar
2 RTSFC Free Shuttle Bus
3 U9 Unilink
4 U6 Unilink
5 X11 Xelabus
IF YOU HAVE ANY QUESTIONS ABOUT STARTING COLLEGE, TAKE A LOOK BELOW. PLEASE TALK TO OUR ADMISSIONS TEAM IF YOU HAVE ANY OTHER QUERIES. YOU CAN FIND THEIR CONTACT DETAILS AT THE BOTTOM OF THE PAGE.
Applications open in mid-September for those wanting to start college the following year. We recommend applying by the end of March to secure a place on your preferred courses and receive an invitation to our transition events.
To apply for a place at Richard Taunton Sixth Form College, visit our website and fill out our online application form. Once we have received your application we will invite you in for a pre-enrolment interview to discuss your course choices and answer any questions that you may have.
When completing the application form, apply for courses that interest you. At your pre-enrolment interview we’ll discuss your course choices in more detail and provide you with lots of help and guidance.
You will be able to try out various subjects at our Applicant Event, so don’t worry if you change your mind - nothing is finalised until your enrolment.
You will spend a minimum of 14 hours a week in lessons, but you also need to factor in time for preparation and enrichment activities.
You are then expected to spend the same amount of time on independent study, outside of your lessons.
Absolutely! You will be invited to our Applicant Event in the Summer term which is a fantastic opportunity to try out a number of subjects and get a feel for what is right for you.
If you are a year 10 student you also have the opportunity to attend a taster day through your school. Speak to your careers team or your Head of Year to find out more.
That’s no problem! Your course choices are not finalised until enrolment, which takes place in August, after you have received your GCSE results.
We will keep you well informed about your young person’s progress at college, and we endeavour to keep our communications open and clear.
There are many ways you can engage with us, and stay informed, during their studies. Please visit the Parent Information pages on our website to find out more.




We aim to combine academic excellence with ambitious career goals to give our young people the very best start in their working life. We believe that by bringing our vision, mission, and values together, we will enhance opportunities for our students and staff, our community, and our region.
Our key aims show that we are focused on inclusion with the firm belief that every young person deserves an equal opportunity to shine and to achieve the best outcome for them. We encourage our staff to become a community of teaching and learning professionals, linked closely with industry and other partners relevant to our curriculum. We are committed to welcoming education providers who share our ambition, vision and values. Together we can continue to build an outstanding inclusive education Trust.
www.lighthouselearningtrust.ac.uk